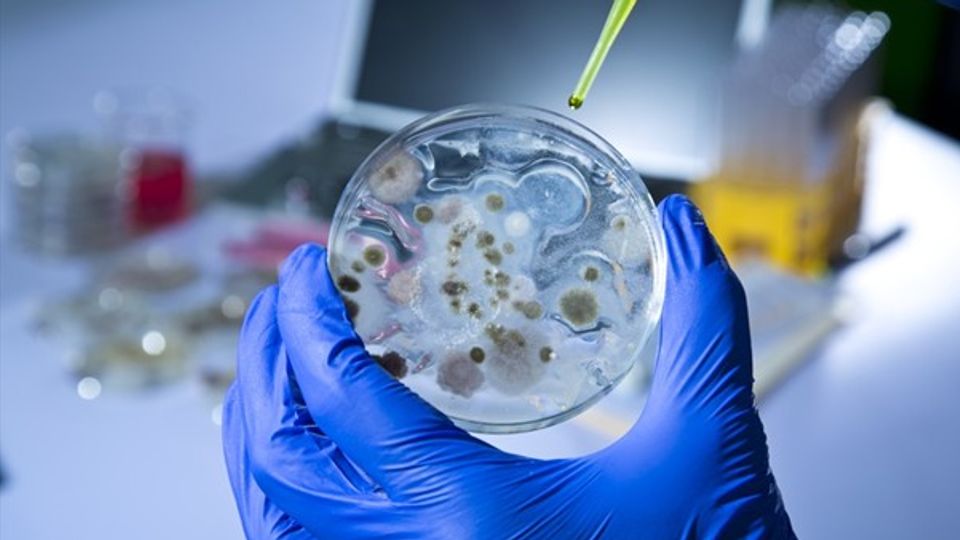
Bacterial colonies in a petri dish prepared for SoluLyse bacterial protein extraction.

Efficient Extraction of Proteins From Bacterial Cells
SoluLyse™ from Amsbio is a bacterial protein extraction reagent that provides a highly efficient yet gentle method for extracting soluble proteins from bacterial cells.
Based upon a proprietary non-ionic detergent formulation, with the SoluLyse™ reagent there is no need for time-consuming and cumbersome secondary treatment methods such as sonication or freeze thaw. The unique, mild SoluLyse™ formulation allows perforation of bacterial cell walls without denaturing proteins.
In addition, the SoluLyse™ reagent offers an up to ten-fold increase in the yield of soluble proteins when compared with other commercial lysis reagents.
Treatment of bacterial cells with SoluLyse™ results in rapid and efficient extraction of proteins that are suitable for affinity purification and analysis. The SoluLyse™ reagent may also be used for preparation of high purity inclusion bodies from total cell lysates.
Employing a simple and quick 1-step protocol - SoluLyse™ is proven to provide superior large-scale bacterial protein extraction and high-throughput cell lysis results. A recent study published in PNAS Nexus (OUP, 2025) highlighted SoluLyse™ as an effective reagent for high-throughput membrane protein research, demonstrating its performance in demanding applications. Broad compatibility with bacterial strains such as E. coli BL21 and affinity systems (GST, His), makes SoluLyse™ a plug-in reagent for protein-expression labs.

